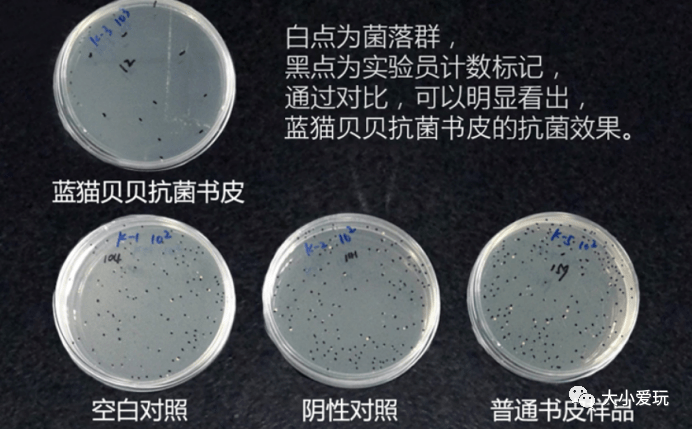
开学季好物推荐如期而至!笔,书包,书皮,学习桌,护眼灯......到底应该

菌落群

粉色的小蘑菇群落
图片尺寸658x892
全自动数菌落,你觉得数的准吗
图片尺寸1080x810
裴氏着色真菌在sda上的菌落特征_食品微生物检验_食品检测技术_食品图
图片尺寸500x391
gb4789平板法测大肠菌群计数,vrba上菌落很典型,但是不产气是怎么回事
图片尺寸450x600
急求:请教如何识别大肠菌群在结晶紫中性红琼脂(vrba)上典型菌落 - 第
图片尺寸480x520
急求:请教如何识别大肠菌群在结晶紫中性红琼脂(vrba)上典型菌落 - 第
图片尺寸1024x768
尹烨:22分钟漫谈菌群
图片尺寸4000x2250
开学季好物推荐如期而至!笔,书包,书皮,学习桌,护眼灯......到底应该
图片尺寸692x429
大肠菌群在伊红美蓝平板上的菌落形态是怎样的? - 食品微生物检测 -
图片尺寸737x672
是真的吗? - 美篇
图片尺寸1600x1200
真菌也能搞艺术🎨
图片尺寸1080x1351
棒状菌群
图片尺寸893x680
群落的相对稳定_word文档在线阅读与下载_免费文档
图片尺寸1080x810
生活饮用水中总大肠菌群在伊红美蓝琼脂上的菌落是怎样的? - 食品微生
图片尺寸691x921
食品微生物检验沙门氏菌检验常用培养基原理解析_菌落_琼脂_黑色
图片尺寸945x950
2.1微生物的实验室培养ppt_word文档在线阅读与下载_无忧文档
图片尺寸1080x810
上海交大科研团队揭示深海热液烟囱微生物群落的演替 - 上海交通大学
图片尺寸800x319
分享几个emb上的典型菌落照片 - 食品微生物检测 - 食品论坛 - powere
图片尺寸1080x1920
大肠菌群菌落是什么样的 - 食品微生物检测 - 食品论坛 - powered by
图片尺寸2976x3968
大肠菌群接种后不产气,为什么? - 食品微生物检测 - 食品论坛 - power
图片尺寸1080x1920